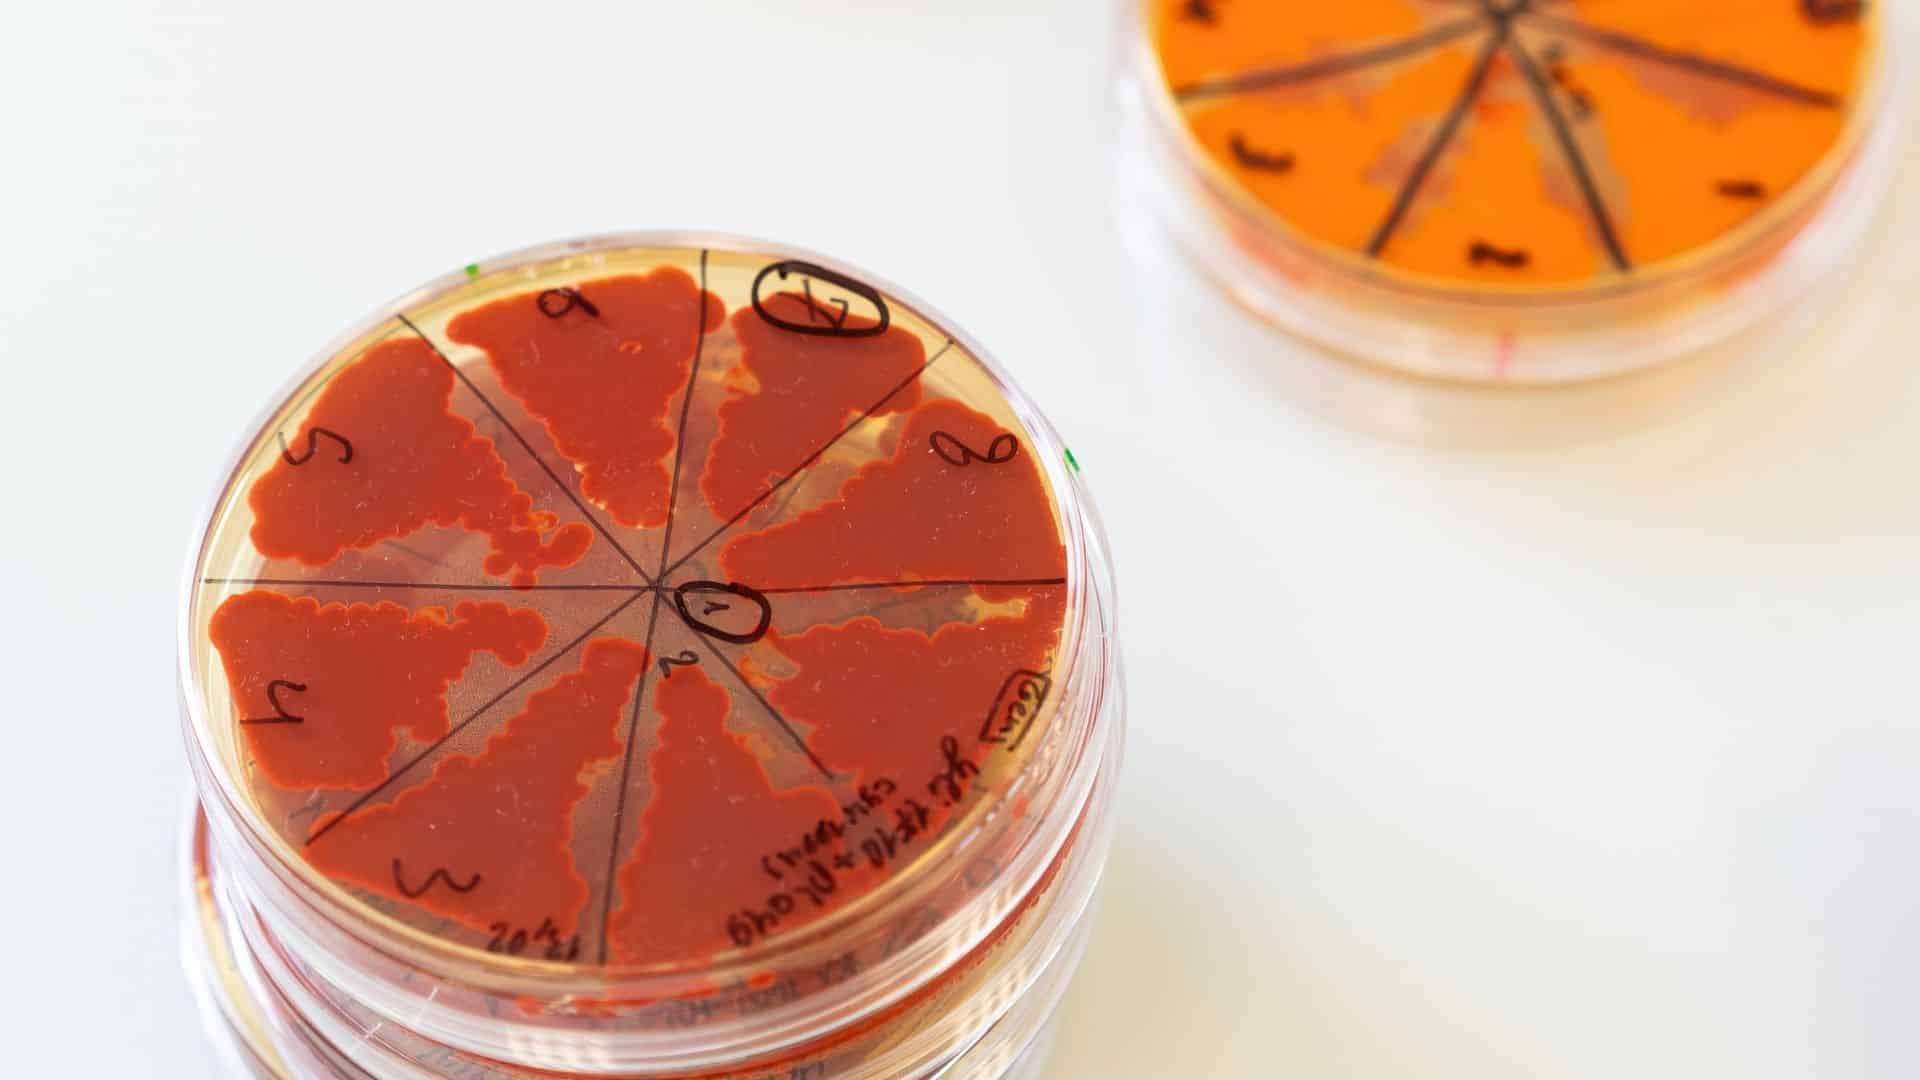
baCta

Startups
Revolutionizing Industrial Ingredients: How Paris’ baCta is Harnessing Microorganisms as Programmable Molecular Factories
Paris-based Biotech Startup baCta Secures €7 Million Seed Funding Round
baCta, an industrial Biotech startup based in Paris, has recently announced the successful completion of a €7 million Seed funding round. The funding was led by LocalGlobe and Daphni, with OVNI Capital and notable business angels, including founders of Phagos, Genomines, and MistralAI, also participating.
Mathieu Nohet, the founder and CEO of baCta, stated, “We are ushering in a new era where microorganisms can be harnessed as programmable molecular factories to efficiently synthesize organic molecules at a commercial scale. This investment enables us to achieve industrial scale for our first ingredient and showcase the value of our unique AI-driven approach, demonstrating our ability to make the supply of industrial ingredients resilient and abundant.”
Established in 2024 by Nohet and Marie Rouquette, baCta’s primary mission is to facilitate the sustainable abundance of valuable molecules. The company leverages AI and precision fermentation to transform microorganisms into programmable molecular factories, producing industrial ingredients.
baCta addresses the soaring demand for industrial ingredients by utilizing synthetic biology, robotics, and generative AI. The company explores genomic “dark matter,” long-range interactions, and regulatory pathways often overlooked by traditional methods, enabling the design of optimized strains with unprecedented speed. Their platform employs bio-based reinforcement learning to reduce costs and accelerate development timelines.
The startup’s initial product, astaxanthin, an antioxidant widely used in various industries, is currently dominated by synthetic versions derived from petrochemicals or expensive natural extraction from microalgae. baCta’s proprietary yeast strain produces an ingredient that serves as a direct replacement, offering competitive unit economics with synthetic alternatives and the premium quality of a natural product.
With the freshly secured capital, baCta aims to expand astaxanthin production, validate industrial processes at pilot and commercial stages, establish a strategic partnership with a French industrial player for production facilities access, and commence commercialization. Additionally, they plan to enhance the platform and expedite the deployment of baCtaForge, their strain engineering platform that combines a Precision Biofoundry and a Genome-to-Factory AI model.
Pierre-Yves Meerschman, co-founder and Managing Partner at Daphni, expressed, “The transition away from petrochemicals is one of the most critical challenges of our time. baCta’s platform approach offers a scalable, economically viable path to replace dirty supply chains with biological factories. Their vision for 2035 aligns perfectly with our thesis on sustainable industrial transformation.”
In October 2024, baCta raised €3.3 million in pre-Seed funding, led by OVNI Capital.
-

 Facebook7 months ago
Facebook7 months agoEU Takes Action Against Instagram and Facebook for Violating Illegal Content Rules
-

 Facebook8 months ago
Facebook8 months agoWarning: Facebook Creators Face Monetization Loss for Stealing and Reposting Videos
-

 Facebook6 months ago
Facebook6 months agoFacebook’s New Look: A Blend of Instagram’s Style
-

 Facebook8 months ago
Facebook8 months agoFacebook Compliance: ICE-tracking Page Removed After US Government Intervention
-

 Facebook6 months ago
Facebook6 months agoFacebook and Instagram to Reduce Personalized Ads for European Users
-

 Facebook8 months ago
Facebook8 months agoInstaDub: Meta’s AI Translation Tool for Instagram Videos
-

 Facebook6 months ago
Facebook6 months agoReclaim Your Account: Facebook and Instagram Launch New Hub for Account Recovery
-

 Apple8 months ago
Apple8 months agoMeta discontinues Messenger apps for Windows and macOS































